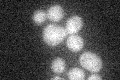
YNL314W
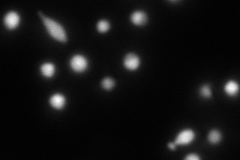
YNL314W
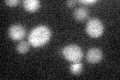
YNL314W
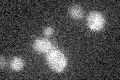
YNL314W

View description
Positive regulator of allophanate inducible genes; binds a dodecanucleotide sequence upstream of all genes that are induced by allophanate; contains an UISALL DNA-binding, a transcriptional activation, and a coiled-coil domain
Localization:
Intensity:
Fold change:
Significance:
-
C’ GFP library in SD
below threshold17.13 -
N' NOP1pr-GFP in SD

nucleus57.9936 -
N' TEF2pr-mCherry in SD
nucleus98.9558 -
N' NATIVEpr-GFP in SD

punctate,nucleus21.8045 -
N' TEF2pr-VC and Cyto-VN in SD

#N/A0 -
C’ GFP library in SD+DTT
cytosol16.850.98No -
C’ GFP library in SD+H2O2

cytosol14.790.86No -
C’ GFP library in Starvation Media
cytosol13.340.77No -
C’ GFP library on the background of Pup2-DaMP

below threshold -
C’ GFP library on the background of CCT mutant

below threshold18.17091.0602No
